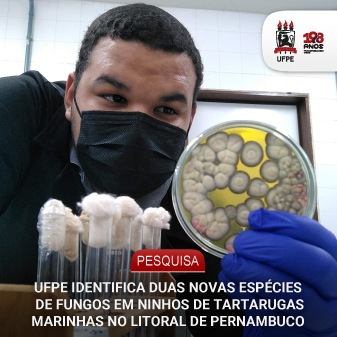

O estudo foi realizado nas praias de Porto de Galinhas, Muro Alto e Maracaípe
Pesquisadores da Universidade Federal de Pernambuco (UFPE) identificaram e descreveram duas novas espécies de fungos associadas a ninhos da tartaruga marinha Caretta caretta (tartaruga-cabeçuda) no litoral de Ipojuca, em Pernambuco. O estudo, intitulado “Aspergillus, Penicillium, and Talaromyces from the sand and eggs of Caretta caretta Linnaeus 1758 nests in Northeastern Brazil with the description of two new species” (em português, “Aspergillus, Penicillium e Talaromyces encontrados na areia e nos ovos de ninhos de Caretta caretta no Nordeste do Brasil, com a descrição de duas novas espécies”), foi conduzido por Gabriel da Silva Ferreira e Maria Betânia Melo de Oliveira, do Programa de Pós-Graduação em Ciências Biológicas da UFPE; Joana Cavalcante de Moura, Cristina Maria de Souza-Motta, Neiva Tinti de Oliveira e Renan do Nascimento Barbosa, do Programa de Pós-Graduação em Biologia de Fungos e do Departamento de Micologia da UFPE; Valdir de Queiroz Balbino, do Departamento de Genética da instituição; Vivian Chimendes da Silva Neves, da ONG Ecoassociados; e Jos Houbraken, do Westerdijk Fungal Biodiversity Institute, na Holanda.
Realizada nas praias de Porto de Galinhas, Muro Alto e Maracaípe, a pesquisa teve como objetivo investigar a diversidade de fungos dos gêneros Aspergillus, Penicillium e Talaromyces presentes na areia e em ovos não eclodidos de ninhos de Caretta caretta. As amostras foram coletadas durante a temporada reprodutiva de 2021 a 2022, com autorização do Instituto Chico Mendes de Conservação da Biodiversidade (ICMBio). Ao todo, 207 isolados fúngicos foram obtidos, sendo 135 pertencentes aos gêneros investigados. Entre as espécies encontradas, duas eram completamente desconhecidas da ciência: Penicillium carettae e Penicillium flavotestudinum.
Os fungos foram identificados a partir de análises morfológicas e filogenéticas, com sequenciamento de DNA e cultivo em diferentes meios de cultura. As novas espécies foram isoladas exclusivamente do interior dos ovos das tartarugas, revelando adaptações específicas a esse ambiente. O estudo também relatou, pela primeira vez, a ocorrência de 19 espécies fúngicas em ninhos de tartaruga-cabeçuda (Caretta caretta) no Brasil, ampliando significativamente o conhecimento sobre a microbiota desses ambientes.
De acordo com o primeiro autor da pesquisa, o estudante de doutorado Gabriel da Silva Ferreira, do Programa de Pós-Graduação em Ciências Biológicas (PPGCB) da UFPE, o trabalho representa uma contribuição inédita para a micologia e para a conservação de espécies marinhas. “Este estudo amplia o conhecimento sobre a biodiversidade de micro-organismos em ecossistemas costeiros e contribui para estratégias de conservação das tartarugas marinhas”, afirmou o pesquisador.
As amostras e tipos das novas espécies foram depositados na Micoteca URM Professora Maria Auxiliadora Cavalcanti (WDCM 604) e no Herbário URM Padre Camille Torrend (HURM), ambos pertencentes à UFPE, que abrigam uma das maiores coleções de fungos da América Latina.
O artigo foi publicado na revista científica Mycological Progress, da Sociedade Micológica Alemã, editada pelo grupo Springer Nature. O periódico possui fator de impacto 2,4, sendo uma das principais referências internacionais na área de micologia. O estudo completo pode ser acessado pelo link.